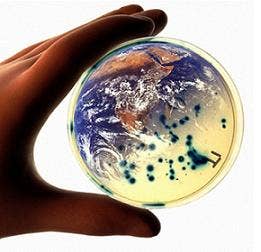
Hand holding a transparent cap with cells in side

The Changing Rights to Family Life in Australia: Biomedicine and Legal Governance in Globalisation
The Changing Rights to Family Life in Australia: Biomedicine and Legal Governance in Globalisation
Note: Dr Sonja van Wichelen left ICS for The University of Sydney in January 2015.
Researcher: Dr Sonja van Wichelen
Funding: Australian Research Council (opens in a new window), DECRA
Period: 2014-2017
» Fact sheet (opens in a new window)(PDF, 165KB)
This project investigates the impact of globalisation and biomedicine on the legal governance of family life in Australia by examining transnational surrogacy arrangements and family reunification in immigration. The research moves beyond a critique of human rights and considers how the meaning of family is affected by science, capitalism, and humanitarianism. This investigation will improve the public and legal understanding of the changing paradigms of family life in an era of globalisation.'
A combination of court transcriptions and document analysis with interviews will be carried out at multiple sites, including family courts in NSW, ACT, Victoria, Queensland and the Permanent Bureau of the Hague Conference on Private International Law (HCCH) in the Netherlands. Participants include lawyers (immigration and family law) and representatives of advocacy organisations (migrant and surrogacy).
Australia has often prided itself on being a conscientious citizen and upholder of human rights on a global level. This project will examine laws and processes where there are still difficulties for modern family-making, particularly in the areas of migration and surrogacy. The results will assist policy makers and other practitioners in ensuring that moral and ethical dilemmas are dealt with in ways that will assist and benefit Australian families.